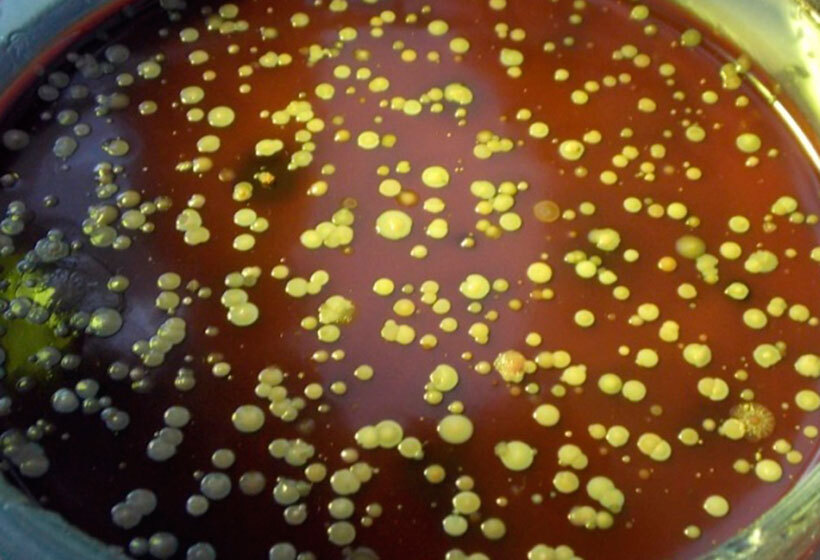

«Советский хлебушек» плесневел через 2 дня, а современный не портится неделю. Почему?

"Поставь самовар, слышишь, да вот возьми ключ, да отдай Мавре, чтобы пошла в кладовую: там на полке есть сухарь из кулича, который привезла Александра Степановна, чтобы подали его к чаю!.. Постой, куда же ты? Дурачина! Эхва, дурачина! О, какой же ты дурачина!.. чего улепетываешь? Бес у тебя в ногах, что ли, чешется?.. ты выслушай прежде: сухарь-то сверху, чай, поиспортился, так пусть соскоблит его ножом, да крох не бросает, а снесет в курятник. Да смотри ты, ты не входи, брат, в кладовую, не то я тебя, знаешь! Березовым-то веником, чтобы для вкуса-то! Вот у тебя теперь славный аппетит, так чтобы еще был получше! Вот попробуй-ка пойди в кладовую, а я тем временем из окна стану глядеть.
– Им ни в чем нельзя доверять, – продолжал он, обратившись к Чичикову, после того как Прошка убрался вместе с своими сапогами" (Помещик Плюшкин, "Мёртвые души", Н.В. Гоголь).
Звучит забавно, но нынешнее население России до сих пор пребывает в странном убеждении, что все "натуральные" пищевые продукты просто обязаны быстро портиться. И неважно, что это за продукт: хлеб, мясо, молоко или колбаса, граждане уверены: чем быстрее продукт портится, тем меньше в нём вредной "химии".
И именно такую точку зрения, за отсутствием иных аргументов, стали продвигать некоторые читатели в ходе обсуждения одной из статей местного автора, посвященной хлебу времён СССР (Вся правда о "советском хлебушке").
В комментариях, помимо прочего, читателями было подхвачено такое суждение: советский хлеб плесневел на второй-третий день потому, что он был "полностью натуральный", а современный лежит без порчи неделю, ибо "напичкан химией".
Ну что же: сегодня читатель узнает настоящие, а не вымышленные причины, по которым "советский хлебушек" так быстро подвергался порче, а современный может ждать своего потребителя целую неделю.
Уровень производства
Начнём с того, что уровень технической оснащённости предприятий хлебопекарной промышленности в СССР и в современной России сравнивать так же нелепо, как "Запорожец" и "Mercedes-Benz".
Сравните сами.
В СССР:

"Больше грязи, толще морда". Зато какой вкусный будет хлебушек!
Наши дни:

Да разве в таких условиях можно изготовить настоящий хлеб?! На эту стерильность смотреть противно: плюнуть и то некуда!
Хорошо, по многочисленным просьбам трудящихся возвращаемся в СССР:

Без слов...

Картина маслом, но не сливочным. Кто-то говорил, что только в России к хлебопечению привлекают нечистоплотных мигрантов?
"Вкусный хлебушек" готов – пора ему и на склад готовой продукции:

Суровая антисанитария и немытые руки пролетариев только добавляли советскому хлебу его недостижимый ныне вкус. Хорошо, если перед этим строители коммунизма не отходили... хм, по своим "надобностям" до отхожего места, или не почесали там, где чесалось.
Доставка в магазин
ГОСТ 8227-56 "Хлеб и хлебобулочные изделия. Укладывание, хранение и транспортирование", введённый в СССР в действие в 1957 году, требовал, чтобы предназначенные для перевозки хлеба автомобили, повозки, тара и брезенты содержались в чистоте, осматривались и очищались перед погрузкой и укладыванием хлеба и хлебобулочных изделий, а также периодически подвергались санитарной обработке.
Но зачем заморачиваться, если строители коммунизма и так всё раскупят и съедят?

Изобретательно! Жаль, что руки не двухметровые.
Быть может, в СССР это просто было модно?

Не жемчужные ожерелья на шеях буржуек, но хлебобулочные изделия на предплечьях боевых подруг строителей коммунизма.
Путь к прилавку
Хлеб доставлен в магазин; настала пора резать часть "кирпичиков" на половинки и – в торговое помещение его.

Для оценки мягкости хлеба покупателями висела специальная двузубая вилка - жаль, в кадр попала только верёвочка.
Свободный доступ к хлебу использовался гражданами для важнейшей процедуры: нужно было убедиться, что хлеб свежий, а не "ночной"; для этого использовались свои пальцы – немытые, разумеется:

Помнём один кирпичик, но возьмём другой: чистота – залог своего здоровья!
Часть хлеба нарезалась прямо за прилавком:

Перчатки?! Чистоплюйство не к лицу ни труженикам советской торговли, ни покупателям!
Путь до дома
В чём донести до дома хлеб – в сетке-авоське, хозяйственной сумке, в руках?
У кого что было, в том и несли купленный в магазине хлеб:

Не беда, что продукты разные - вместе нести удобнее. Тем более, в желудке всё равно всё перемешается
Пакетов для хлеба в СССР не было, а в бумагу его заворачивать было не принято: не масло ведь, и не сыр.
Хлебница
А где же ещё хранить хлебобулочные изделия, принесённые из магазина?
В каждой семье была хлебница, в которой хранился свежекупленный хлеб: металлическая, эмалированная, пластмассовая, из бересты, деревянная - резная или обычная, покупная или самодельная:

Хлебницы требовалось содержать в чистоте и регулярно мыть, но многие хозяйки этого не делали. Зачем? Ведь это хлеб, а не мясо!
Так почему плесневел советский хлеб?
Наверное, внимательный читатель уже догадался: на всём своём пути от хлебокомбината до стола потребителя хлеб подвергался обсеменению микроорганизмами (грибы, в том числе плесневые; бактерии; споры бактерий и грибов, и пр.), которые в хлебнице – в невентилируемом закрытом пространстве - начинали бурно развиваться, приводя к порче продукта.
Результаты бакпосева из проб воздуха, отобранных в обычном продуктовом магазине
Надо ли удивляться тому факту, что советский хлеб быстро плесневел, а современные производители хлебобулочных изделий стремятся изолировать свою продукцию от внешней среды: воздуха, загрязнённых поверхностей и пр. такими упаковочными материалами, как викет-пакеты (с клипсой), flow-pack – трёхшовные герметичные пакеты, или термоусадочная плёнка?
Только так – разумеется, при соблюдении требований ГОСТ 31752-2012 к технологии упаковывания хлебобулочных изделий – и удаётся сейчас достичь срока годности хлеба в 5, а то и 7 суток.
Посему таинственная "химия" и "антибиотики" в современном хлебе, благодаря которым он якобы и хранится целую неделю - это всего лишь досужие вымыслы журналистов, предназначенные исключительно для развлечения почтеннейшей публики.
Хотите – верьте, хотите – нет.
Вы храните хлеб в магазинной упаковке или в хлебнице?










Проголосуйте, чтобы увидеть результаты
Если у вас возникли вопросы по теме данной публикации, вы всегда можете написать мне в мессенджеры или позвонить:



Я думаю сейчас он хранится долго из-за того что в тесто добавляют химию или еще что.
Да, всякие улучшители-разрыхлители! Он и невкусный, просто как губка.
Плохо видать у вас в Питере с хлебом. В Новосибирске пекут разный хлеб. Вкусный и невкусный, есть хлеб как губка, а есть рыхлый и с хрустящей коркой-такой же как пекли у бабушки в деревне. Бездрожжевой, на сыворотке, да какой хошь. Местные даже пекут хлеб, для ностальгирующих по 16 и по 24 рубля. От того ничем не отличается. Ещё одно воспоминание осталось с СССР, это выброшенный хлеб на помойках. Много. Валялся на дороге и у мусорных баков. Четвертинки, полубуханки и даже целиком выкидывали.
Ну не совсем согласна с тем что в Питере хлеб валялся. Ленинградцы к хлебу относились уважительно, во всяком случае, те кто общался с блокадниками уж точно никогда бы на помойку не выкинули. И в булочной можно было купить и половинку и четвертинку. В Узбекистане, кстати, тоже никогда не валялся, там даже малышня, если бежит мимо куска лепешки, обязательно останавливались, возвращались и как минимум клали на скамейку. Ну и раньше в городах на лестницах на каждом этаже были для пищевых отходов бачки, которые дворники выносили каждый день, а в деревнях хлеб шел на корм тем же свинкам. То, что Вы видели хлеб на помойках, еще совсем не значит, что так было везде, и уж советская власть в этом точно не виновата. Это, извините, уже недостатки воспитания тех, кто хлеб выбрасывал. В семье не без урода, так и было, и есть, и будет.
Ну а что касается хлеба сейчас в Питере, то пекут его много где, и ассортимент огромный, но даже если и есть где-то настоящий, на закваске, без дрожжевой, то он и стоит столько, что не всякий себе сможет такой позволить. И, кстати, в СССР не использовали сухие дрожжи, были живые. Разница для человеческого организма есть. Вредны и те, и те на самом деле, но вот сухие - яд смертельный.
Ну да,в Питере не видел такого. Это правда.
Вот такого не видел нигде, а поездил я немало. Это в каком году и где такое было?
Так было много где. Интересно вас слушать. Сейчас власть во всех грехах виновата, а советская нигде ни при чём?
В Ленинграде в 1965 г точно было, до этого не очень помню, маленькая была. И было это до конца 70 х точно. И в центре города, и в новостройках. Кстати, и в Брянске я была в 70-71 г, точно не помню, там помоек как таковых вообще не было. Приезжала во двор машина и люди выносили мусор, а бачки пищевые были и там.
Разница между советской и нынешней огромна - мягко сказано. Сейчас никто ни за что не отвечает. Воруют миллиардами, и выходят из зала суда с мизерными штрафами... При советской власти так не борзели, каждый отвечал за свою работу, и на любого чиновника и управленца, на любого директора завода и нач. цеха можно было найти управу. Слетали с должностей, судили и сажали за воровство у государства, 15 лет с конфискацией, а Прим - так вообще вышка. Конечно, воровало и начальство, конечно тащили с производства и люди - кто что ог, несуны из называли... но делали это с оглядкой, и не так нагло как сейчас, и были и проверки, и контроль на проходных, и если уж попадались - редко кто отделывался просто испугом.
А сейчас что?
Напрасно смеетесь, это не смешно, а грустно. Травят нас по полной программе. Со всех сторон. Ладно бы американцы со своим ГМО, но вот наши же, свой же народ...
ну а на счет дрожжей как-нибудь выберу время и соберу данные что такое пищевые искусственные дрожжи, и как они действуют на чеовеческий организм.
В Москве, в 60-х, точно стояли, рядом с мусоропроводом, ведра с крышками - для пищевых отходов. И их регулярно заменяли на чистые.
Везде стояли бачки я думаю года до 70 и вМоскве и в Куйбышеве и во многих городах.
Были вёдра в подъездах, которые забирали раз в неделю... тараканьи полигоны. Мы выкинули эту прелесть через пару недель...)))
В Питере хлеб никогда не валялся на улицах. Я жила там когда-то и могу сказать, первое что бросилось мне, краснодарке, в глаза: на улицах не валяется никакая еда! А вот в нашем городе...
Вы мил человек врите, да уж не завирайтесь, в Советском союзе никогда не было ни мусорных баков ни тем более мусорных контейнеров, во двор в одно и тоже время приезжал мусоровоз, и все с ведерками бежали выносили мусор, и никогда мусор не валялся во дворе, тем более хлеб, с какой целью вы вообще пишите такую лабуду)))
Сколько себя помню при Союзе, а это больше 20 лет, никакой беготни с вёдрами не было, по крайней мере в Ленинграде и областных городах и посёлках. Во многих домах был мусоропровод, а на лестничных площадках - вёдра для пищевых отходов, которые достаточно часто меняли, так что ни мух, ни запаха не было. Во дворах были площадки с мусорными баками, куда выносили мусор из домов, где не было мусоропровода. Кстати, многие площадки для мусора до сих пор на тех же местах, только убирают их реже.
В серединн 70-х у меня бабушка поменялась из Ленинграда в областной посёлок, так там бегали, но не с вёдрами, а с бидонами - несколько раз в неделю по окраинам посёлка привозили в бочках молоко с ближайших ферм, хотя в центре посёлка каждый день летом с утра бочки стояли около магазинов - мы с друзьями на великах за молоком ездили в каникулы. Хотя в бутылках и пакетах в магазинах можно было купить любую молочку в любое время.
Мусор выбрасывали в любое время, а пищевые отходы или в компост, или соседям, у кого живность какая-то была.
Как там сейчас - даже не представляю, потому что даже поездка за город не по карману и дыра в бюджете. А раньше - каждые выходные...
Правильно думаете! Посмотрите, сколько КОНСЕРВАНТОВ - сплошная таблица Менделеева! Разрыхлители, удерживатели влаги, экономят даже на сахарном песке и добавляют что-то дешевое... А потом удивляются сплошным аллергическим реакциям и БА, к пульмонологу уж НЕ протолкнуться!
С аллергией - к аллергологу, у пульмонолога «другая специализация».
К чему Ваш сарказм... любой переизбыток химических добавок приводит к заболеваниям легких.
Я часто сама пеку хлеб (и белый, и серый, и Бородинский), и разумеется никакой химией его не пичкаю. Неделю зАпросто не плесневеет, а Бородинский и две недели.
Запутался я в комментариях, не знаю уже, что кому чего ответить, но в пику Медведеву Дмитрию Владимировичу и в угоду Вам, Татьяна, скажу, что советский хлеб за неделю только черствел и даже сильно, а чтобы он заплесневел через 2 дня, его действительно надо было выкинуть на помойку, там ребятишки типа бактерий приложут свой хоботок. Я и сам хлебушек таскал в авоськах вместе с бутылками молока, кульками сахара, пачками масла и т.п., ничего в этом нет криминального, как говорят в Африке: "Всё чики-пуки."
Моя тётка в деревне один раз, в выходной, пекла хлебы на всю семью на неделю, иначе нельзя, тоже работала. Семья большая - 8 человек. В конце недели выпеченный хлеб не терял вкус и запах, только немного черствел. Это так, для информации к размышлению.
Я так же не помню чтоб хлеб плесневел, он просто черствел, конечно если на него попадет вода, то мог и заплесневеть. Сейчас хлеб храним в холодильнике но через неделю начинает пахнуть плесенью.
Сейчас и в муке добавки...)
Ничего он не хранится. Через 2 дня уже плесневелый.
Свой хлеб хранится больше недели, а на сколько не скажу-съедается быстро: две булки по 700 г на семью из 3 человек хватает на 5 дней. Вкуснотень, а магазинный через 3 дня выкидывать.
Советский хлеб черствел, но никогда не плесневел. А сегодня хлеб плесневеет уже в магазине.
Совершенно верно, сегодня не только плесневеет, но и противно чернеет! Позавидуешь хлебу из 70 - 80 годов!
Я бы не сказала, что он хранится долго - через три дня зеленый... А в советское время такого не было.
Видел, как пекли советский хлеб. Грязные чаны, текущее масло из редукторов, какие-то люди в грязных халатах и фуфайках. У них всегда имелась бражка и самогон, дармового сырья для браги и самогона полно. Сейчас любая мини-пекарня при магазинах имеет такое оборудование, какое никому не снилось при СССР. Я покупаю горячий свежий хлеб в магазине, где имеется мини-пекарня. Цена пшеничного и урожайного хлеба была 24 руб. за булку, недавно хлеб стал дороже, 26 руб. за булку. К вечеру этого хлеба нет, разобрал народ. Не понимаю рыдающих о коммунистическом рае в СССР. Денег мало? Шевели мозгами. Мозгов нет? Шевели руками.
Замечательно сказано, Николай Александрович.
а пенсионерами и инвалидам, которые в силу возраста и инвалидности уже шевелить руками-ногами не могут, и в силу воспитания, при наличие ясности ума, высшего образования, в интернет-мошенники не пойдут, тем-то что делать?
Так что сначала свои мозги включите, подумайте, на сколько этично выглядят такие советы.
Повторяться - дурной тон, милейший.
Впрочем, вам это даже к лицу.
Да, на самом деле в магазине пекут хлеб. Горячий хлеб можно купить. Причем в бумажном пакете продают. Можно заказ сделать, они оставят хлеб.
Да.конечно сейчас все условия для людей, но хорошего хлеба не покушаете. Он внутри пустоватый и корка толстая. А где хлеб?
Наталья Эдуардовна, я не охотница до хлеба. Но хлеб я и сама дома пеку, и в магазине покупаю. По поводу пористости, то зависит от того как готовили. Вы же сами знаете. В чабатте вообще крупные неравномерные поры. Вот такой у меня хлеб на своей закваске. Поры в пшеничном покрупнее, в ржаном помельче. Корочки тонкие. Мне тоже толстая корка не нравится.
А если нет ни мозгов, ни рук - шевели шароварами, особенно на пешеходном переходе.
Интересно.
Может быть не совсем хорошо помню. Но мне помнится, что хлеб раньше быстро черствел, а не плесневел. Да, из вчерашнего хлеба, из остатков делали сухарики.
Не всегда покупаю хлеб. Когда покупаю всегда смотрю дату изготовления. Вчерашний не покупаю, только свежий. Хлеб выбираю, какой нравится. Не считаю, что сегодня хлеб хуже, чем 30 лет назад. Раньше хлеб был более грубый, толстые корки. Пожилые корки обрезали и ели мякиш. Берегли зубные коронки, протезы. Помню модно было с золотыми коронками ходить. А золото мягкий металл, быстро истирается.
Хранить хлеб рекомендуют в холщевых мешочках в хлебнице, тогда он не плеснеевеет.
Как раз в то время появилась практика срезания с хлеба корок и использования только мякоти при приготовлении мясного и рыбного фаршей.
Обычай этот остался до сих пор, хотя большинство поваров и признаёт, что это - атавизм, оставшийся от той эпохи.
Но корки всё равно срезаем: привычка.
Да, фарш все делали дома. Для мясного фарша использовали мякиш белого нарезного батона. Его, мякиш, предварительно замачивали в молоке, потом добавляли в фарш. Когда котлетки жарятся, хлеб впитывает жир и он не вытекает из котлет. Котлеты получаются более сочными и мягкими. Так учили.
Нет, корочки не срезаю. Дома в тостере подсушиваю ещё. Если подсушивать ржаной хлеб, то приятный, вкусный запах появляется.
Эксперт, как правило один. Семейные фотографии очень любят женщины демонстрировать. Свои достижения в жизни.🌹
Мужчины некоторые тоже - чтобы не так сильно их били: типа, "у меня же семья!".
Вот только это не спасает.
До 90-х я как-то не задумывалась сколько весит хлеб. На самом деле вроде бы стандартный хлеб, но вес его везде был разный. На сегодняшний день существует ГОСТ по хлебу, где указан стандартный вес для каждого вида хлеба. Менее указанного веса нельзя выпускать хлеб с таким названием. По ГОСТу нет хлеба весом 300 гр. Продавать можно и часть хлеба.
Мне удобно покупать 300 гр-200 гр. То что покупаю называется "булочка", а не хлеб.
Не надо хвалить современный хлебушек и не надо наговаривать на хлеб при СССР. Всё что вы написали в статье одна ложь. Даже не хочу об основывать.
Так вам обосновывать-то нечем.
А насчёт лжи - хотя бы один пункт приведите, дабы не быть в ряду пустозвонов.
Лично не присутствовал в процессе изготовления, транспортировки, хранения хлеба не сейчас, не тогда, но за всю свою жизнь увидел, что на хлебе появляется плесень только сейчас, не успел полностью съесть за 2-3 дня и всё, не куда не денешься приходится идти против своего принципа "выбросить хлеб это преступление" плесень проявляется во всей красе. Может в те времена этого не наблюдалось по причине того, что съедался хлеб за один день (помню школьником каждый день ходил в магазин, обязательные, ежедневные покупки были хлеб и молоко), но сейчас нормативно разрешено остатки не реализованного хлеба использовать при приготовлении теста, может в этом причина.
И даже если не съедался за один день, то жарили гренки (в деревне, любой ребёнок, это мог) или сушился в духовке (это уже родители). Так что - в доме всегда был мешочек с сухарями.
Соответствующий уровню оставляемых комментариев.
Нет.
Как и медицинское.
И прочие, перечисленные в профиле.
А также две учёные степени.
Вообще, уровень вашего мышления напоминает завистливо-детский.
Что ни разу не удивительно.
Я выскажу только своё мнение, оно моё и только моё, основываясь на простой логике (образование техникум по профилю химия, и высшее военное по профилю радиационная и химическая защита, всю жизнь проработал занимаясь вопросами радиационной и химической защиты населения), образование, честно говоря особой роли не играет. Основываюсь на реальном опыте и можно сколь угодно долго и глубоконаучно раскрывать проблему с теоретической точки зрения, но главное то практический результат. Ну не видел я заплесневевшего хлеба в советский период, а вот сейчас сколь угодно. И вывод свой делаю на основе практических наблюдений. И последнее, в основном хлеб пеку сейчас сам, он со временем высыхает, но еще не было случая, чтобы на нем образовывалась плесень, так что где СанПИ соблюдается тщательнее еще вопрос.
Естественно, адресовано милейшему местному автОру...
Михаил Алексеевич, это не довод.
"Если к вам не прижимаются в метро, это ещё не значит, что метро в Париже не существует" (© "Ищите женщину").
Нарушите условия хранения - повышенная влажность воздуха, в первую очередь, - плесневые грибы не заставят себя ждать.
Уважаемый Дмитрий Владимирович! Вашими же словами отвечу "это не довод", и поясню, вернее спрошу, почему когда лежит покупной хлеб условия благоприятные для плесени, а когда самопеченый нет, и так уже лет 5-7.
Положите образцы хлеба после 10-минутной экспозиции для сравнительного исследования в одинаковую среду - скажем, термостат, и сравните результат через 3 суток.
Всё увидите сами.
Про какие условия хранения Вы говорите-ОКСТИСЬ! Да-а-а, в квартирах, домах прям обязательно старались сохранить, а если нет ну прям все в Советском Союзе в плесневатых гребках! Ха-ха-ха!